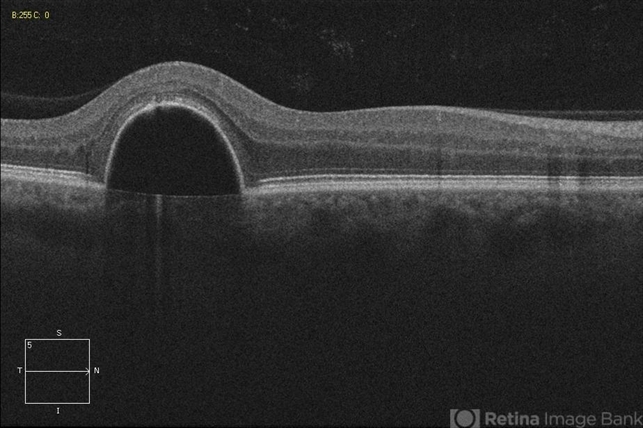
file

-
 By John S. King, MD
By John S. King, MD
Retina Associates, PA - Uploaded on Aug 27, 2012.
- Last modified by Jennifer Hicks on Aug 30, 2012.
- Rating
- Appears in
- Miscellaneous
- Condition/keywords
- idiopathic serous detachment of the retinal pigment epithelium
- Photographer
- Kristin Konecki, OcuSight Eye Care Center, Rochester, NY
- Imaging device
-
Scanning laser ophthalmoscope
Cirrus

Initializing download.
Initializing download.










